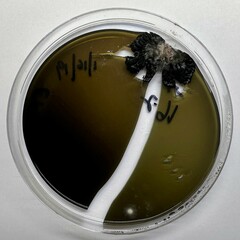
Penicillium commune
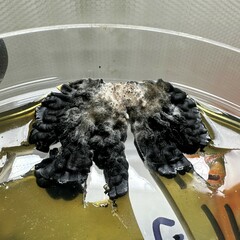
Penicillium commune
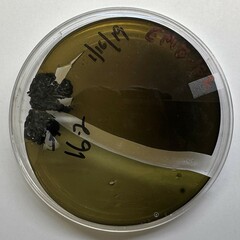
Penicillium commune

Penicillium commune: taxon details and analytics
- Domain
- Kingdom
- Fungi
- Phylum
- Ascomycota
- Class
- Eurotiomycetes
- Order
- Eurotiales
- Family
- Aspergillaceae
- Genus
- Penicillium
- Species
- Penicillium commune
- Scientific Name
- Penicillium commune
Summary description from Wikipedia:
Penicillium commune
Penicillium commune is an indoor fungus belonging to the genus Penicillium. It is known as one of the most common fungi spoilage moulds on cheese. It also grows on and spoils other foods such as meat products and fat-containing products like nuts and margarine. Cyclopiazonic acid and regulovasine A and B are the most important mycotoxins produced by P. commune. The fungus is the only known species to be able to produce both penitrem A and roquefortine. Although this species does not produce penicillin, it has shown to have anti-pathogenic activity. There are no known plant, animal or human diseases caused by P. commune.
...Images from inaturalist.org observations:
We recommend you sign up for this excellent, free service.